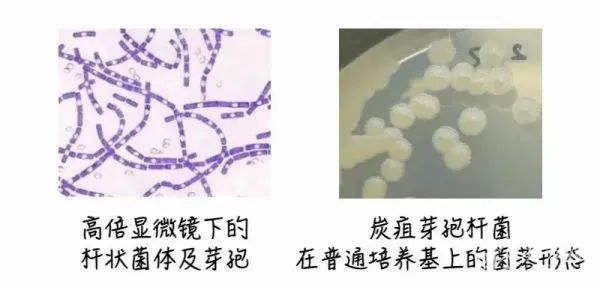
汛期是炭疽高发期 疾控提醒：主要有三种感染途径

7月1日,我国全面进入主汛期。长江流域、太湖流域、珠江流域西江等地强降雨持续。汛期是炭疽高发期,特别是洪涝灾害后,暴雨冲涮导致疫源地土壤中的炭疽芽孢杆菌暴露地表,汛期家畜抵抗力下降,容易受到病原侵袭,炭疽流行和发生风险增大。今天(7月6日),江苏疾控也发布了相关提醒。

炭疽的名称来自古希腊文“anthrakos”,意思是“煤炭”,是因典型皮肤炭疽的黑痂而得名。炭疽是由炭疽芽胞杆菌引起的一种人兽共患病,是《中华人民共和国传染病防治法》规定的乙类传染病,其中肺炭疽按照甲类传染病管理。
根据感染途径分为皮肤炭疽、肺炭疽、肠炭疽等类型,人间炭疽病例以皮肤炭疽最为常见,肺炭疽及肠炭疽少见但病死率高。我国炭疽自然疫源地分布广泛,主要分布在西部和东北部地区,近年来每年都有十几个省份报告炭疽病例,多为散发,聚集性疫情时有发生。
炭疽的流行曾遍及全世界,给人类生命财产造成了巨大灾难,人们认识这种疾病并与其斗争亦有100多年的历史。炭疽芽胞可在环境中长期存在。一般是食草动物首先感染,患病动物(如牛、马、羊、骆驼等食草动物)的血液、粪尿排泄物、乳汁、以及病死畜的内脏、肉类、骨骼直接感染人类或污染环境,是感染的重要来源。被炭疽芽孢杆菌污染的动物制品也可能成为传染源。病人作为传染源少见。
炭疽主要有三种感染途径:(1)经皮肤接触感染:皮肤接触到污染物中的炭疽芽胞杆菌细菌就会通过皮肤上的微小伤口进入体内。(2)经口感染:主要因摄入污染食物而感染,与饮食习惯和食品加工有关。(3)吸入性感染:吸入污染有炭疽芽胞的尘埃或气溶胶,一般情况下直接吸入感染较少见,最常在皮毛加工厂的工人中发生。当炭疽芽胞被作为生物武器使用时,这种感染方式则最常见。
草食动物易感,常见于羊、牛、马、驴、骡、骆驼、象、鹿等。杂食动物如猪、狗等也有发病,肉食动物如虎、豹、豺、狼等食用炭疽病兽肉也会造成感染。人对炭疽易感,易感性无种族、年龄与性别的差异,是否发病主要取决于接触机会和接触方式,青壮年因职业(农民、牧民、兽医、屠宰场和皮毛加工厂工人等)关系与病畜及其皮毛和排泄物、带芽胞的尘埃等的接触机会较多,是感染发病的高风险人群。
炭疽的临床表现是什么?潜伏期1~5日,最短仅12小时,最长12日。临床可分以下五型:皮肤炭疽:皮肤直接接触病畜及其皮毛而感染。多见于面、颈、肩、手和脚等裸露部位皮肤。此外还有肺炭疽、肠炭疽、脑膜型和败血型。
建议广大市民,不接触、不宰杀、不购买、不食用病死和不明原因死亡的牛、羊等牲畜,不生食畜产品。如有可疑接触史和不适症状,要及时就诊,患者隔离治疗。炭疽病人的治疗,在进行规范抗生素治疗的同时,还应特别注重建立有效的支持治疗。禁忌对皮肤炭疽病例的皮损做外科切开引流。
点击右上角
微信好友
朋友圈

点击浏览器下方“
”分享微信好友Safari浏览器请点击“
”按钮

点击右上角
QQ

点击浏览器下方“
”分享QQ好友Safari浏览器请点击“
”按钮
